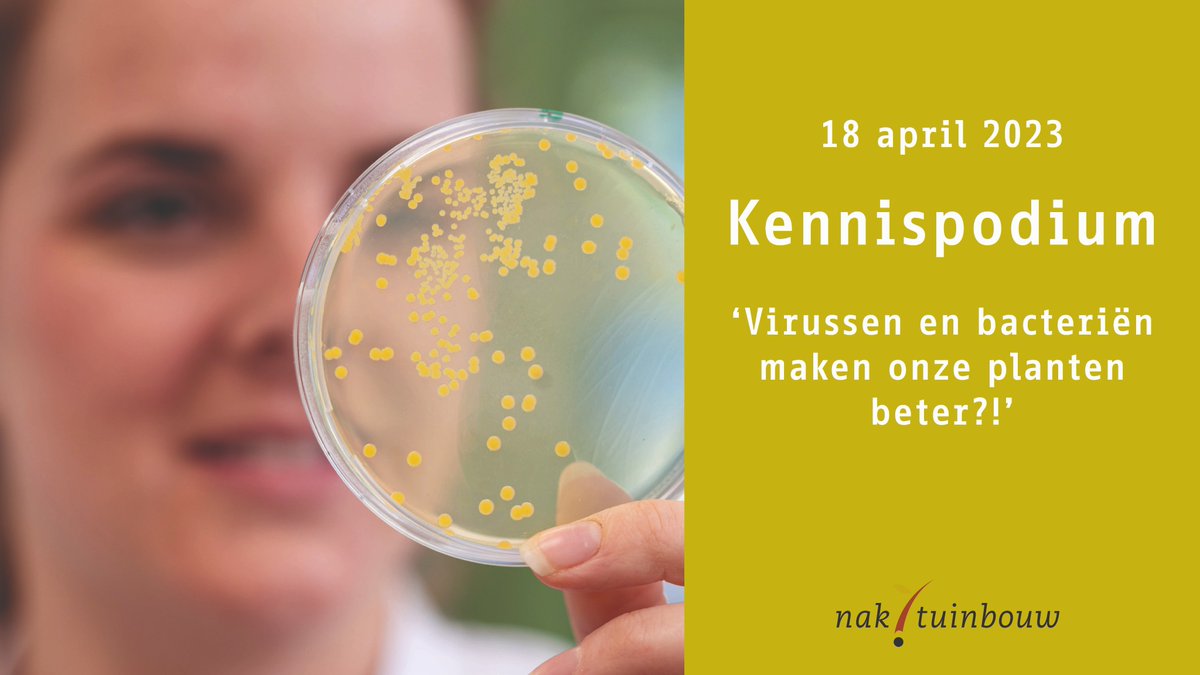
VBN tweet media

VBN
223 posts

VBN
@VBNinfo
De Vereniging van Bloemenveilingen in Nederland is een overkoepelende organisatie van de Nederlandse coöperatieve sierteeltveilingen.
Katılım Mayıs 2013
663 Takip Edilen571 Takipçiler

Per 1 januari 2025 splitsing van het kenmerk S53 #Potmateriaal in 2 kenmerken: S53 Potmateriaal #ompot en S99 Potmateriaal #kweekpot en invoering van kenmerk #I02 voor de #planthoogte-#ranges. bit.ly/3YHYVQP
Nederlands

Opschorting van #invoerheffingen naar het #Verenigd #Koninkrijk op bloemen van niet-EU-oorsprong. bit.ly/3U7U6iG
Nederlands

Wees zeer alert op #tabakswittevlieg “#Bemisia tabaci” in #zonnebloemen “#Helianthus annuus” naar het VK en voorkom afkeuringen! bit.ly/3QjSpNo

Nederlands

De introductie van #uitheemse #mieren vindt vooral plaats door het meeliften met #pot- en #kuipplanten. Risico's van uitheemse mierensoorten in kaart gebracht. bit.ly/3XJfhrB
Nederlands

Vanaf 11 juli intensivering #inspecties #Mandevilla bestemd voor #Verenigd #Koninkrijk. bit.ly/3Nt8WeU
Nederlands

Op dinsdagmiddag 18 april organiseert #Naktuinbouw weer een #kennispodium voor geregistreerde bedrijven en bestuurders. Het onderwerp is: #Virussen en #bacteriën maken onze planten beter?! bit.ly/3KatJn4
Nederlands

Met ingang van 2 maart 2023 is import van plantmateriaal vatbaar voor #Xylella #fastidiosa niet langer toegestaan voor 13 derde landen. bit.ly/3J31Bly
Nederlands

Intensivering #inspectie planten bestemd voor #Verenigd #Koninkrijk - #Euphorbia pulcherrima (#kerstster) en #Solanum pseudocapsicum. bit.ly/3ERc5Td
Español

Wijzigingen #landeneisen Verenigd Koninkrijk. Vanaf 1 oktober veranderen de eisen voor planten bestemd voor opplant, van #Viburnum, #Camellia en #Rhododendron, met uitzondering van R. simsii. bit.ly/3RJbypF
Nederlands

Per 1 juni 2022 verplichting van voorbehandelingsmiddel #Florissant 830 voor #Helleborus. bit.ly/3kEpmTY
Nederlands

Uitstel invoering #Brexiteisen #fytosanitair certificaat voor snijbloemen. De NVWA meldt dat deze datum met vijftien maanden wordt verschoven tot 1 oktober 2023. bit.ly/3LAzA3D
Nederlands

Importinspectie op #wortelknobbelaaltje #Meloidogyne enterolobii bij #Ficus en #Philodendron. bit.ly/3EzEXNI
Nederlands
